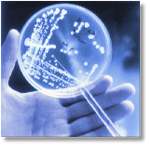

|
ANALYTICAL DEVELOPMENT
LABS
|
|
PAST
|

-
To PRESENT

|
|
-
|
|
Active Pharmaceutical
Ingredient
DEVELOPMENT
|
|
|
|
-
|
|
-
|
|
|
|
Physical Parameters
of Active Material
|
|
|
|
Stereo
microscope
|
|
-
|
|
ANALYTICAL INSTRUMENTATION
|
|
Modelling - Crystal
Morphology and IR Analysis
|
|
|
|
-
|
|
-
|
|
Modelling - Crystal
Morphology and IR Analysis
|
|
|
|
-
|
|
-
|
|
Crystal habits - Polymorphism
- Crystal Lattice Structure
|
|
|
|
-
|
|
-
|

API DEVELOPMENT |
|
Alternative
API Pathways
|
|
|
|
Reactor - Development of Active Ingredient
|
|
-
|
|
-
|

BULK ACTIVE MATERIAL SCALE-UP |
|
|
|
3rd Party JV
SCALE-UP REACTOR & LIG BIO-EXTRACTOR
|
|
-
|
|
-
|

ANALYTICAL TESTING |
|
Drug Substance Physical
& Chemical Profile
|
|
|
|
-
|
|
-
|
|
DRUG SUBSTANCE - IMPURITY
PROFILES
|
|
|
|
-
|
|
-
|
|
MICROBIOLOGICAl TESTING
|
|
HEPA - Laminar Flow
- Aseptic Practice - Barrier Protection
|
 -- -- - - |
|
-
|
|
-
|
|
Microbial Spread Plate
- After Innoculation & Incubation
|
|
|
|
-
|
LIG's
'Piggy Back' Policy (VIEW)
-
|




 --
-- --
--
 --
-- --
--
 --
-- --
--






 --
-- -
-